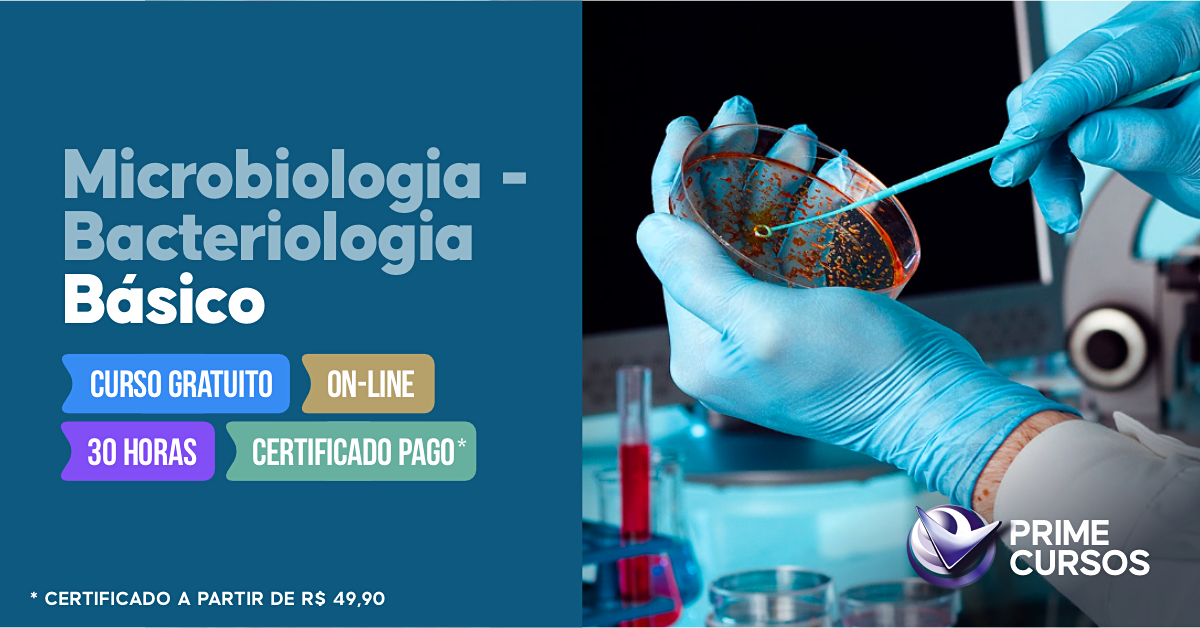
Curso de Microbiologia - Bacteriologia Básico

Área do Aluno
Curso de Microbiologia - Bacteriologia Básico Online Grátis
Este curso é GRÁTIS. Aproveite!.
Totalmente livre de mensalidades.
 ASSINAR GRÁTIS*
ASSINAR GRÁTIS*Curso grátis de Microbiologia - Bacteriologia Básico - com opção de certificado válido!
O que estuda a Microbiologia?
A microbiologia, basicamente, é o ramo da ciência que se dedica ao estudo dos microrganismos, que são seres vivos invisíveis a olho nu, e que precisam ser estudados por meio de um microscópio. Os microrganismos podem ser seres unicelulares, multicelulares ou acelulares. Da mesma forma que os microrganismos podem se dividir por tipos, o estudo destes seres também possui sub-disciplinas de pesquisa, que se especializam de acordo com o tipo selecionado: vírus, bactérias, protozoários, fungos, algas.
O que estuda a Bacteriologia?
A bacteriologia é um ramo de estudo ou especialidade dentro da microbiologia que estuda especificamente as bactérias: sua morfologia, genética, bioquímia, comportamento, ecologia, etc. O estudo das bactérias é fundamental para a ciência biológica, tendo em vista tanto as possibilidades benéficas destes pequenos seres para o meio ambiente e para a vida humana (como na produção de alimentos e medicamentos), como também o seu enorme potencial patogênico (como as doenças: cólera, tuberculose, meningite, leptospirose, etc).
Este curso apresenta uma das mais importantes áreas da Microbiologia: a Bacteriologia. Com o estudo dos micro-organismos e principalmente das bactérias, podemos conhecer a fundo como agem estes pequenos organismos, seus possíveis benefícios e malefícios e a forma como reagem a inúmeros tipos de ambientes e condições; e assim, tanto nos proteger deles, como também utilizá-los a nosso favor.
Com o seguinte conteúdo programático:
O que é a Microbiologia
Evolução da Microbiologia
Microbiologia como ciência
Classificação
Características de Cada Grupo de Microrganismos
Características das Bactérias
Célula Bacteriana e Suas Partes
Colorações Mais Frequentes Na Rotina De Bacteriologia Clínica
Espécies Mais Frequentes Na Rotina Do Laboratório Clínico
Provas De Identificação De Bactérias
Tabela De Identificação Do Gênero Ou Espécie Bacteriana
Cocos Gram-Positivos
Bacilos Gram-Negativos Não Fermentadores
Urocultura
Hemocultura
Cultura de Ponta de Cateter
Líquor
Teste de Sensibilidade aos Antimicrobianos
Resistência Bacteriana a Antimicrobianos
Bibliografia/Links Recomendados
| FICHA DE INFORMAÇÕES |
|---|
| Embasamento Legal: nossos cursos têm base legal constituída pelo Decreto Presidencial nº 5.154 e nossa metodologia segue as normas do MEC através da Resolução CNE nº 04/99. |
| Pré-requisitos: não há pré-requisitos para esse curso, sugere-se ter Ensino Médio completo (não obrigatório). |
| Carga Horária do Certificado: 30 horas |
| Objetivos: curso livre para Qualificação Profissional onde você aprenderá: o que é a microbiologia, evolução da microbiologia, microbiologia como ciência, classificação dos microrganismos, características de cada grupo de microrganismos, características das bactérias, célula bacteriana e suas partes, colorações mais frequentes na rotina de bacteriologia clínica, espécies mais frequentes na rotina do laboratório clínico, provas de identificação de bactérias, tabela de identificação do gênero ou espécie bacteriana, cocos gram-positivos, bacilos gram-negativos não fermentadores, urocultura, hemocultura, cultura de ponta de cateter, líquor, teste de sensibilidade aos antimicrobianos, resistência bacteriana a antimicrobianos. |
|
Vantagens do Certificado: * Atualizar seu Currículo, aumentando suas chances para conquistar um bom emprego; |
Se você gostou desse curso, pode gostar também de:

Pacote Office

Informática Básica
Curso de Microbiologia - Bacteriologia Básico
Este é um curso estrelas. Total de 24 avaliações.
2 meses atrás (10-09-2025)
Muito bom, estudando certinho respeitando os cronogramas no final da tudo certo. As vídeos aulas são ótimas, gostaria de parabenizar a todos do curso prime estão de parabéns
9 meses atrás (22-01-2025)
Um ótimo curso mais bem difícil para entender mais tudo bem vai da certo me ajudar muito no conhecimento que são muitos.
1 ano atrás (27-02-2024)
Muito bom esse curso RECOMENDO. Me ajudou muito no meu aprendizado gostei muito muito valeu a pena
1 ano atrás (02-02-2024)
A maioria dos cursos depende primeiramente do esforço de quem está fazendo, é como se nós colocássemos prioridade e atenção em que lemos, todos os cursos são excelentes em informações, parabéns.
1 ano atrás (07-12-2023)
muito importante pois tras conhecimentos de grande aprendizagem na area da micro ampla diversidades de estudos a serem ultilizados em diversos campos